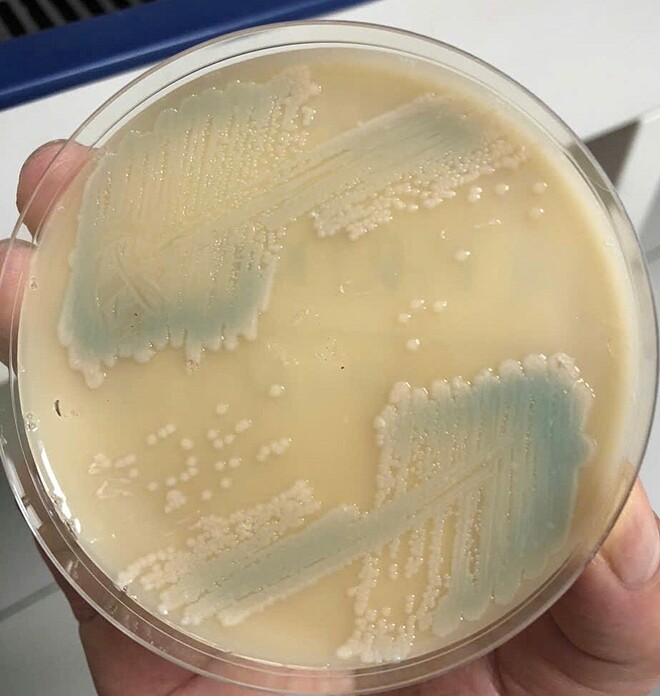

Hai người suy đa tạng do nhiễm vi khuẩn 'ăn thịt người'
2024-09-04 HaiPress
Người đàn ông 43 tuổi làm công nhân giao hàng đông lạnh ở một tỉnh phía Nam. Một tháng trước khi nhập viện,anh sốt cao liên tục,đi khám và điều trị nhưng không đỡ. Khi vào Bệnh viện Đa khoa Hòa Bình hồi cuối tháng 8,người bệnh sốt cao,rét run,suy hô hấp,sốc nhiễm khuẩn,suy đa tạng.
Kết quả xét nghiệm xác định nhiễm khuẩn huyết do vi khuẩn Whitmore,còn gọi vi khuẩn ăn thịt người. Các bác sĩ chỉ định thở máy,lọc máu liên tục,dùng thuốc vận mạch,sử dụng kháng sinh phổ rộng,trong đó có kháng sinh đặc trị bệnh Whitmore. Hiện bệnh nhân vẫn nguy kịch,bác sĩ Hoàng Công Tình,Khoa Hồi sức tích cực 1,Bệnh viện Đa khoa Hòa Bình,cho hay hôm 4/9.
Còn người phụ nữ 59 tuổi,tiền sử bệnh đái tháo đường,xuất hiện sốt cao,khó thở,đau tức ngực hôm 1/9. Kết quả chụp cắt lớp vi tính có hình ảnh đám mờ đông đặc và tràn dịch màng phổi 2 bên. Bệnh nhân được cấy máu,kết quả cho thấy nhiễm vi khuẩn gây bệnh Whitmore. Hiện sức khỏe bà đã ổn định.
Hình ảnh kết quả cấy máu của bệnh nhân nhiễm vi khuẩn Whitmore (vệt xanh lam). Ảnh: Bệnh viện cung cấp
Whitmore sống trong đất,đường lây nhiễm chính là các vết trầy xước trên da tiếp xúc đất,nước có vi khuẩn; hoặc qua đường hô hấp khi hít phải các hạt bụi đất chứa vi khuẩn. Hàng chục năm qua,bệnh Whitmore gần như biến mất,xuất hiện lại trong vài năm gần đây.
Hiện chưa có vaccine phòng bệnh này. Vì vậy,bác sĩ khuyến cáo người dân nên chủ động chống bằng cách ăn chín,uống nước đun sôi để nguội,đảm bảo vệ sinh,an toàn thực phẩm. Không giết mổ,ăn thịt động vật,gia súc,gia cầm bị ốm chết; hạn chế tiếp xúc trực tiếp với đất,nước bẩn,ở những nơi ô nhiễm nặng,khi cần tiếp xúc cần sử dụng đồ bảo hộ ví dụ găng tay,ủng... Không nên tắm gội,bơi,ngụp lặn ở các ao,hồ,sông tại hoặc gần nơi bị ô nhiễm.
Khi có vết thương hở,vết loét hoặc vết bỏng,cần tránh tiếp xúc với đất hoặc nước có khả năng bị ô nhiễm. Nếu bắt buộc phải tiếp xúc,hãy sử dụng băng chống thấm và cần được rửa sạch đảm bảo vệ sinh.
Những người có bệnh nền như tiểu đường,bệnh gan,thận,suy giảm miễn dịch... cần được chăm sóc,bảo vệ các tổn thương để ngăn ngừa nhiễm khuẩn. Khi nghi ngờ nhiễm bệnh,cần vào viện để khám,điều trị kịp thời.
Thúy Quỳnh